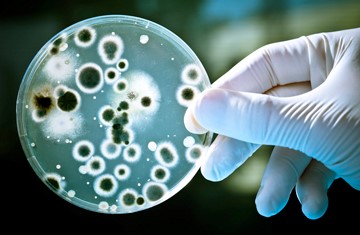

| India-Coimbatore and Erode |
Thiruvasagam
Shree Sakthi Agency |
+91 9443722373 |
thiruvasagam71@gmail.com
shrisakthied@gmail.com |
| India-Chennai |
Daniel Gandhi
Benaiah Projects |
+91 9176975863 |
daniel@benaiahprojects.com |
| India-Tiruppur |
Narayan
|
+91 9842257745 |
udumalainarayan@gmail.com |
| India-Bangalore |
Rajendran
Matrika Marketing |
+91 9343462830
+91 9844982951 |
matrikamarketing@gmail.com |
| India-Mangalore |
M J Shetty
Lakshmi Sales Corporation |
+91 7353655544 |
lakshmicryo@gmail.com |
| India-Kerala |
Joseph Attokaran
Super Aqua |
+91 9447721149 |
joattokaran@hotmail.com |
| India-Kerala |
Nujoom Mohammed
Ecodew |
+91 9020661101 |
nujoom@ecodew.solutions |
| India-Kerala |
Sudheesh
Pristine Aqua |
+91 9995900700 |
sudheeshkgnair@gmail.com |
| India-Mumbai |
Rajesh Gulhane
|
+91 9702661555 |
raajgulhane@gmail.com |
| India-Goa |
Nadkarni
Vinayaga Business Solutions |
+91 9404455401 |
nyn.goa@gmail.com |
| India-Pune |
Joel Varghese
Myles Green Solutions |
+91 8888828423
+91 9834674609
+91 2026951311
+91 2048609769 |
mylesgreensolutions@gmail.com |
| India-Pune |
R Nair
Pristine Aqua |
+91 7021778615 |
rkpnair2007@gmail.com |
| India-Maharashtra |
Amol Pingale
ADP Enterprises |
+91 7977550496 |
adpenterprise33@gmail.com |
| India-Mumbai, Maharashtra |
Ninad Deshpande
Accede Associates |
+91 9820845007 |
ninad@accede.net.in |
| India-Maharashtra |
Sheetal Kumar
Aaradhya Enterprises |
+91 8485008668
8605017181 |
aaradhyasales1@gmail.com |
| India-Hyderabad |
Sirish Reddy
General Marketing Corporation |
+91 9000361000 |
sirishind@gmail.com
kushikaushik@gmail.com |
| India-Madhya Pradesh |
Sailesh Jain
Dhanraj Agencies |
+91 9425153529 |
dhanrajagencies1@rediffmail.com |
| India-Gujarat |
Vijay Bhagat
Gumandev Minerals |
+91 9998064844 |
gumandevminerals@gmail.com |
| India-Gujarat, Maharashtra |
Sailesh Sharma
I Lux Lighting |
+91 9923445805 |
iluxlighting1@gmail.com |
| India-Gujarat |
Jalendhu Pathak
Om Sai Enterprises |
+91 9328211223 |
jalendu.pathak@omsaienterprise.in |
| India-Punjab |
Raj Pal Singh
Noble Products |
+91 9814393940 |
39noblepro@gmail.com |
| India-Delhi |
Ajit Singh
Enhanced Wapp Systems |
+91 8527196443 |
ajit.singh@wappsys.com |
| India-Delhi |
Suresh Nair,Manoj Kumar
Greentech Environmental Solutions |
+91 9990376561
8800418100
9953534308 |
manoj.consultants@gmail.com
info@greentechenviro.co.in |
| India-Karnataka |
Nishikant
Healthy Sip |
+91 7406864966 |
npurker@gmail.com |
| India-Punjab, Haryana |
Avinash Gupta
Satya Enterprises |
+91 7678498157 |
satyaenterprises.zkp@gmail.com |
| India-Ahmedabad |
Sourabh Kumar Jha
J&J Enterprises |
+91 8758601168 |
jjenterprise.mail@gmail.com |
| India-Andhra Pradesh |
Ratna Kumar Jetty
Divya Dhatri Conglimerate |
+91 9535410000 |
ratna@divinearth.in |
| India-Maharashtra |
Sudhir Hukumchand Jain
Vardhman Trade Serve |
+91 8275722935 |
sudhirj1008@gmail.com |
| India-Odisha |
Ranjit Singhnayak
Greenectar Enterprises |
+91 8480943843, 9937564621 |
greenectar.odisha@gmail.com |
| India-Karur |
Vinoth Kumar
Spring Aqua Tech |
+91 9865744400
915042195 |
kukimpex@gmail.com |
| India-Haryana |
Sachin Rajput , Amit Sharma
Hindustan Water Care |
+91 958999336 |
hindustanwatercare_h@yahoo.com |
| India-Assam |
Chinmoy Sharma
North east green tech pvt ltd |
+91 9954075753,8822115665 |
csharma@gmail.com |
| India-Gujarat, Maharashtra |
Sailesh Sharma
Isha Ecotech |
+91 9923445805 |
ishaecotech.nsk@gmail.com |
| India-Gujarat |
Sunil Shridhar
Image Consulting Associates |
+91 9825066249 |
imageglobalmarketing@gmail.com
swathi shridhar@hotmail.com |
| India-Goa |
Florian Rebello
Petrose Enterprises |
+91 7021121829 |
rebelloflorian@gmail.com |